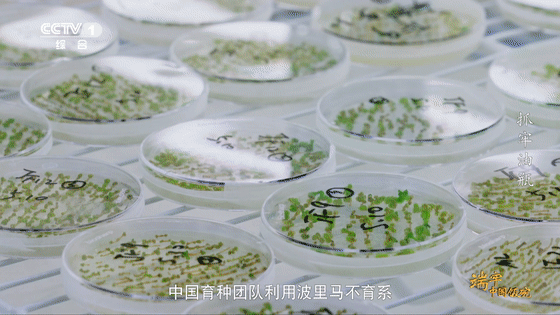

摆锅、开火、热油
散下食材
烟汽升腾
香味四起
火光铲影间
锅内色变
伴着调料的游走
最终完成一场美妙的结合

在中国人心目中
油的地位仅次于主食
有了油
才有了烹炒煎炸
才有了活色生香的中华美食
那又是谁
塑造和成就了它呢?

超有才的“油菜院士”
“让油菜亩产再多一些
让农民种粮有钱挣”
这是中国工程院院士傅廷栋
多年来努力的目标和方向

如今已年过八旬的他
仍然坚持每天到田里
观察油菜的生长情况
寻找提高油菜产量的方法

60年如一日的辛勤耕耘
终不负有心人
傅廷栋发现了
世界上第一个有实用价值的
油菜波里马雄性不育类型
让油菜增产成为可能
如今
他已经培育出
15个品种的优质杂交油菜
累计推广面积约1亿亩

傅廷栋说:
“责任就是创新的动力”

正因为众多像傅廷栋一样
勇担责任、不懈努力的
育种专家相继涌现
才得以让中国油料逐步实现增产
让农民增收的路走得稳健坚实
党的十八大以来
中国育种团队利用波里马不育系
育成油菜杂交种超过200个
累计推广面积约10亿亩
全国油菜籽生产总量
提高了131.4万吨
如今达到了1471.4万吨
成果傲人!
不服输的农机专家
8月
是许多农户收割的时候
对于湖北省江陵县的
种植大户张斌来说
可谓忙上加忙
他要尽早在收割后的水稻田里
种下油菜

从前
由于人力成本和收获损失率“双高”
许多农户
对油菜种植的积极性较低
想要加大冬闲田扩种
提高油菜种植效率和收益
机械化耕作是关键

为此
农业农村部油菜机械化
专家组组长吴崇友
日复一日地和团队
进行油菜收割机的研发、实验
和升级换代工作

这项工作执行起来
远比想象中更难
不仅要保证机器体型小巧
能在南方的小块田中作业
同时必须确保有足够高的割晒台
方便采收身材高挑的油菜
在此基础上
还要降低机械损耗
解决油菜籽容易脱落这一难题
保证食用油供给

吴崇友说:
“只有我们把这个机器
研发得更完美了
才可能在生产当中发挥作用”

如今
他们已经对油菜收割机进行了
6次升级换代
力争将油菜收获总损失率
降到8%以下
随着机械化耕作的推进
长江流域的冬闲田
越来越多地被利用起来
油稻轮作带来的
良好经济收益
吸引了更多
像张斌这样的种植户返回家乡
他们满满的信心
得益于“藏粮于技”在中国大地上
结出的骄人果实

了不起的“花生大拿”
在我国
花生是仅次于
东北大豆和南方油菜籽的
第三大食用油原料
但花生的种植和培育
并不容易

今年6月
位于花生主产区的
河南正阳县农户们
就曾急红了眼
由于遭遇干旱天气
种子迟迟不能下地
而推迟播种
将直接影响花生的产量

为此
河南省农业科学院
花生首席科学家董文昭和团队
将耐旱的花生种子
在河南进行了推广

10年来
他们一直在为花生科研
夜以继日地奔忙
一方面
是要研发出具有
抗病性、抗旱性、耐涝性等特点的
能够应对特殊天气的花生品种
另一方面
是要在保证花生稳产的同时
提高花生出油率和油酸含量
这也就意味着
要大面积推广种植
高油酸优质花生品种

党的十八大以来
全国有近80个
像董文昭这样的科研团队
投身花生研发
超过100个花生品种
得到大面积应用
在含油量得到提高的同时
我国的花生亩产
也得到大幅提高

预计“十四五”期间
花生产量可从现在的亩产253 公斤
提高到260公斤

作为世界上最早种植油料作物
制取植物油的国家之一
中国以丰富的油料供给
不断满足着百姓油瓶
东北的大豆油、玉米油
中原产区的芝麻油、西北的胡麻油
山区林地的茶树油、核桃油
正成就着百姓餐桌的幸福密码
构成了中华大地上
流光溢彩的“食用油地图”

更多精彩故事,敬请收看
9月14日(星期三) 18:20档
总台央视综合频道CCTV-1
《端牢中国饭碗》之《抓牢油瓶》
Copyright © 2001-2026 湖北荆楚网络科技股份有限公司 All Rights Reserved
互联网新闻信息许可证 4212025003 -
增值电信业务经营许可证 鄂B2-20231273 -
广播电视节目制作经营许可证(鄂)字第00011号
信息网络传播视听节目许可证 1706144 -
互联网出版许可证 (鄂)字3号 -
营业执照
鄂ICP备 13000573号-1
鄂公网安备 42010602000206号
版权为 荆楚网 www.cnhubei.com 所有 未经同意不得复制或镜像